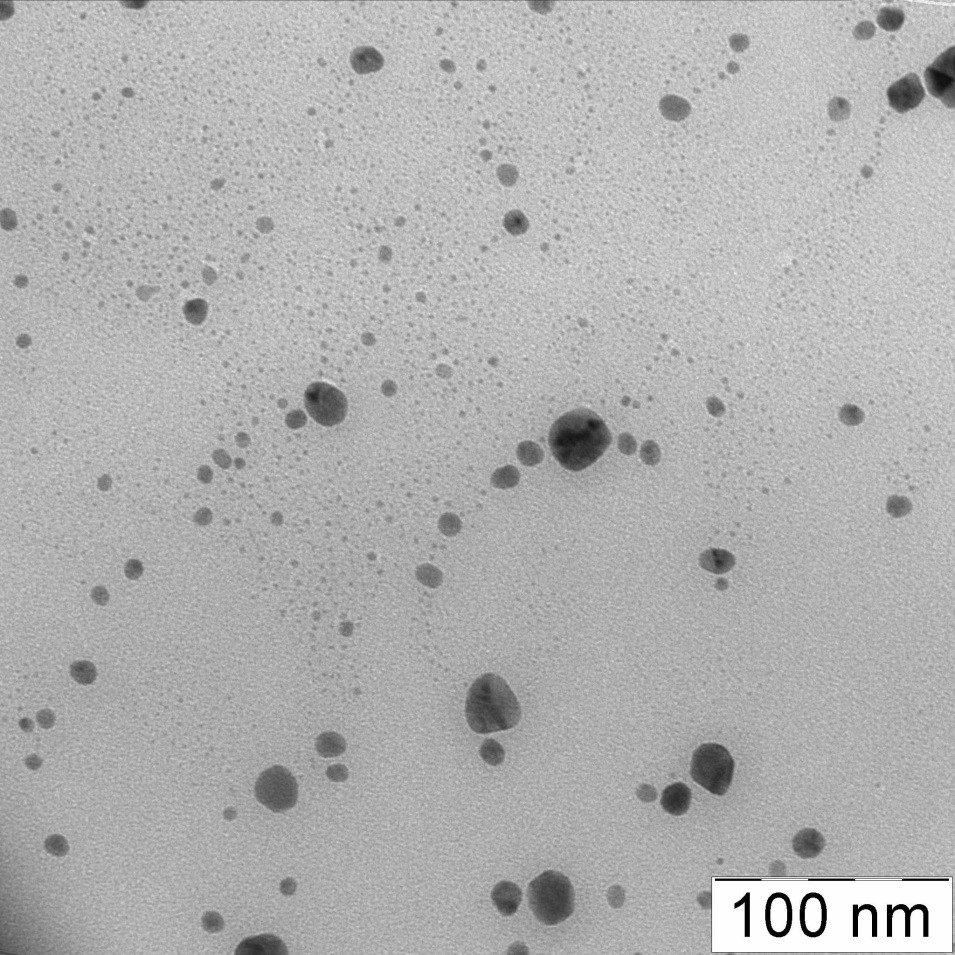

АДРЕС
Красноярск
ул. Республики, 45
Заказчик ЗАО «ЭКОДЕН»
Генеральный директор
Денисов Геннадий Николаевич
ПРОТОКОЛ
лабораторных испытаний.
Проведено исследование дисперсной системы №2, предоставленного ЗАО «ЭКОДЕН». Целью исследования было определение состава систем, а именно: уточнение наличия в растворе резонансных кластеров определенных элементов, а также других веществ, включая ПАВ, определение размеров и концентрации кластеров, а также выработка рекомендаций по перспективным областям применения дисперсной системы.
Спектрофотометрические исследования.
Наличие резонансных кластеров, их концентрация, а также присутствие в дисперсной системе других веществ определялось методом оптической спектрофотометрии с использованием спектрофотометра СФ-2000 (производства СКБ «Спектр», Россия). На рис.1 приведены спектры оптической плотности D в диапазоне длин волн 300 – 800 нм для исходной дисперсной системы, а также для растворов, полученных разбавлением исходного раствора дистиллированной водой. Как следует из рисунка, для всех растворов спектры содержат один пик на длине волны 390 нм. Пик на длине волны 380 – 420 нм характерен резонансных кластеров серебра и обусловлен явлением плазмонного резонанса. Других пиков на спектрах оптической плотности не наблюдается, что свидетельствует о том, что исследуемая дисперсная система представляет собой взвесь резонансных кластеров серебра в воде и не содержит других веществ, включая ПАВ.
Как следует из рис.2, высота пика плазмонного резонанса исходного и разбавленных растворов пропорциональна концентрации резонансных кластеров серебра в растворе. По оценке концентрация кластеров в исследуемом растворе составляет около 0.07 г/л. Раствор может быть рекомендован потенциальным потребителям для входного контроля концентрации кластеров серебра в растворе, а также для выходного контроля концентрации кластеров серебра в материале, если этот материал оптически прозрачен – лаки, полимерные материалы, шампуни и т.п.
Исследование методом динамического светорассеяния.
Размеры кластеров серебра в дисперсной системе определялись методом динамического светорассеяния с использованием прибора «Photocor-Compact-Z» (производства компании Фотокор, Россия). Как следует из рис.4, на котором приведены результаты измерений, прибор зафиксировал наличие 4 характерных размеров кластеров: 0.14 нм; 5.4 нм; 38 нм и 6600 нм. Размер 0.14 нанометров близок к радиусу атома серебра, хотя, необходимо отметить, что достаточную точность прибор имеет только в диапазоне размеров частиц 0.6 – 10000 нм. Пик вблизи 6600 нм характерен для частиц пыли, которые могли попасть в раствор из воздуха в процессе подготовки измерений. Пик 4 – 8 нм, с максимумом на 5.4 нм соответствует, по-видимому, индивидуальным кластерам серебра, а пик 20 – 90 нм, с максимумом на 38 нм – агрегатам кластеров. Частицы агрегируют, поскольку ПАВ в коллоидном растворе отсутствует.
Исследование методом просвечивающей электронной микроскопии (ПЭМ)
Размеры кластеров после испарения растворителя из исследуемого раствора, их структура и состав исследовались методом ПЭМ с помощью электронного микроскопа LEO-912 AB OMEGA (Germany). На рис.5 приведена микрофотография, полученная с помощью указанного микроскопа. Как следует из рисунка, основная доля кластеров имеет размеры от 4 до 12 нм, хотя, встречаются отдельные кластеры размером до 25 нм. Кластеры имеют форму близкую к сферической. Из электронограммы, представленной на рис.5 следует, что кластеры состоят из кристаллического серебра, без заметной примеси оксидов и солей. Размер кристаллитов совпадает с размером кластеров, т.е. кластеры серебра – монокристаллические. Отличие размеров кластеров серебра, полученных методом динамического светорассеяния и просвечивающей электронной мироскопии не вызывает удивления, т.к. первый метод исследует размер частиц непосредственно в растворе, а второй – после удаления растворителя (воды).
Исследование влияния дисперсной системы на некоторые условно патогенные плесневые грибы
Испытания препарата на фунгицидные свойства проводили диско-диффузионным методом. Диски фильтровальной бумаги, пропитанные препаратом, размещали в чашки Петри с заранее посеянным «газоном» плесневых грибов. В качестве тест-культур использовали следующие плесневые грибы: Aspergillius niger, Aspergillius flavus, Penicillium funiculosum, Ulocladium atrum, Chaetomium globosum. Предложенные для испытаний виды плесневых грибов известны как сильные аллергены человека, могут вызывать различные микозы и являются биодеструкторами органических материалов. Через трое суток наблюдали развитие тест-культур на обработанных дисках и вокруг них. По характеру роста и зоне подавления роста определяли биологическую активность препарата, нанесенного на бумажный диск.
По результатам испытаний фунгицидное действие препарата можно оценить как удовлетворительное в отношении грибов Aspergillius niger, Penicillium funiculosum, Ulocladium atrum, Chaetomium globosum; и как хорошее в отношении гриба Aspergillius flavus. Эти данные позволяют считать препарат перспективным для использования его фунгицидных свойств.
Заключение.
Рис.1 Спектры оптической плотности D в различной концентрации.

Рис.2 Зависимость оптической плотности D от концентрации кластеров.

Рис.4 Распределение кластеров по размерам.

Рис.5 Электронная микрофотография кластеров (метод ПЭМ).
Рис.6 Электронограмма исследуемых кластеров.
